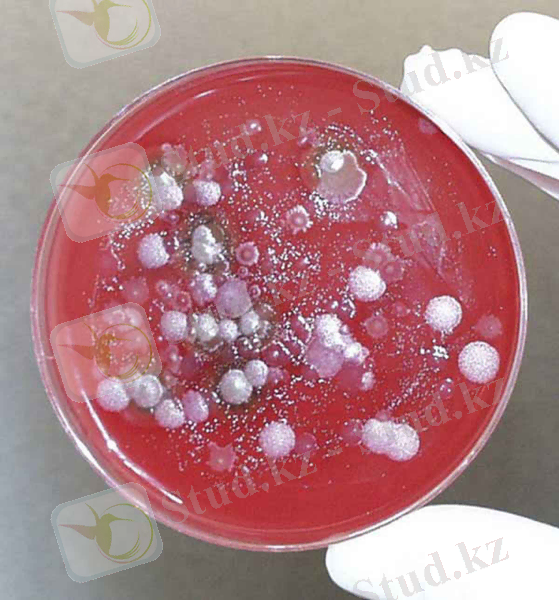
http://www.popsci.com/sites/popsci.com/files/styles/medium_1x_/public/import/2013/images/2010/08/anthrax.jpg

Малдардағы бруцеллезді диагностикалау әдістері


Қазақстан Республикасы Білім және Ғылым министрлігі
Семей қаласының Шәкәрім атындағы Мемлекеттік Университеті
АГРАРЛЫҚ ФАКУЛЬТЕТ
«ВЕТЕРИНАРИЯЛЫҚ САНИТАРИЯ»
КАФЕДРАСЫ.
БӨЖ
Тақырыбы: Бруцеллезді балау әдістері
Орындаған: Онгарова Д
Тобы: ВС-303
Тексерген: Нуркенова М. К.
Семей 2015ж
Жоспары:
I. Кіріспе бөлім:
II. Негізгі бөлім:
2. 1. Бруцеллалардың антигендік құрылымы.
2. 2. Сақиналық әдіс
2. 3. Ажыратып балау.
III. Қорытынды бөлім
IV. Пайдаланылған әдебиеттер
Бруцеллез (Brucellosis ) - созылмалы өтетін, іш тастау, шуы түспеу, эндометрит, орхит және жануарлардың жыныстық қабілетінің бұзылуы арқылы ерекшеленетін жұқпалы ауру. Бруцеллез жер шарының көптеген елдерінде таралған, бірақ сирек кездесетін Африка, Орталық және Оңтустік Америкада. Азия мен Европаның кей елдерінде. Бруцеллезге 60-тан артық үй және жабайы жануарлар түрлері бейім. Әсіресе тез шалдығатындары: сиыр. қой, ешкі, солтүстік бұғысы. Оларда бруцеллез індет түрінде таралады. Түйе, жылқы, марал, қодас, буйвол сияқты жануарларда бәсеңдеу таралады. Ит, мысық, қоян сайғақ, түлкілерде шектеулі дәрежелерде, болмаса спорадия түрінде кездеседі. Бұл аурудың табиғи ошағы болмайды. Инфекция қоздырушысының бастауы бруцеллезбен ауырған малдар жатады, әсіресе клиникалық белгілері айқын білінген кезде өте қауіпті. Ондай жануарлар шаранамен, шумен, тастанды төлмен, жыныс жолдарымен аққан соралармен ауру қоздырушысын аса көп мөлшерде бөліп шығарады. Қоздырушы микроб сонымен қатар сүтпен, шәуетпен, нәжіспен, несеппен бірге бөледі. Сиырдың желінінде бруцеллалар 7-9 жыл, ал қойда 2-3 жыл сақталып, оқтын-оқтын сүтпен бөлініп тұрады. Бруцелалармен ластанған өнімдер және малдан алынған шикізаттар, жануарларды күтуге арналған жабдықтарда, жемшөп, төсеніш, су, топырақ, малды қарайтын адамдардың киімдері басты жұқтыру факторлары болып табылады. Жас төлге бруцеллез негізінен алиментарлық жолмен енесінің сүті арқылы, ал сақа жануарларға алиментарлық жолмен және шығылысқанда жанасу арқылы жұғады. Шаруашылықта ауру жаңадан басқа жақтан мал әкелгенде каратиндеу ережелерін сақтамағанда, ауру және сау малдарды бірге жайганда, бір суаттан суарганда, бір жолмен айдағанда таралады. Ауру қоздырушысын малға ит пен кемірушілер де әкеледі. Әсіресе олар бруцеллезге шалдыққан малдардың шуымен не тастанды төлмен жанаскан жағдайда микроб тасымалдаушыға айналады. Індеттің жаңа ошақтарында бейім жануарлардың 60%-ке дейін инфекцияға шалдығу мумкін. Бас кезінде буаз мал ішінара, ал кейін жаппай іш тастауы мүмкін. 2-3 жыл өткен соң аборт байқалмайды, ал шеттен мал қосқанда індеттену өршіп, жаңа әкелінген және бұрын ауырған малдарды қоса қамтып, тастау қайтадан қаулауы мумкін. Малды араластыру індетті өршітіп, оның жаңа ошақтарын қалыптастырады. Малды өсіргенде, бағып күткенде ветеринарлық- санитарлық талаптарды дұрыс орындамау, соның нәтижесінде жануарлардың ауруға төзімділігінің нашарлауы, уақытылы шумен тастанды төлді жинамау, көңді тазаламау, дезинфекцияны ретті түрде жасамау бруцеллездің шығуына жағдай тудырады. Бруцеллезге диагноз кешенді түрде індеттанулық, клиникалық, аллергиялық, зертханалық тексерудің нәтижесінде қойылады. Бруцеллезге ауылшаруашылық және үй жануарларының барлық түрі, көптеген жабайы аңда мен құстар сезімтал. Тәжірибе жүзінде тасбақаларды, бақаларды және тағы басқаларын зақымдауға болады.


Ірі қара бруцеллезі
Бруцелла бактериялары препараттарда көбінесе ретсіз орналасады, бірақ кейде тізбек түрінде не екі - екіден жататын кездері де болады. Шар түріндегі бактериялардың ұзындығы 0, 3 - 0, 6 мкм, ал сопақша формалар 0, 6 - 1, 5 мкм шамасында болады. Бруцеллалар өздігінен қозғалмайды, спора туғызбайды. Кейбір жағдайларда қабықша (капсула) пайда болуы мүмкін. Электрондық микроскоп арқылы тексергенде бруцеллалардың бір - бірінен және басқа да Грам әдісімен теріс боялатын бактериялардан өзгешелігі байқалмайды. Бруцеллалар барлық анилинді бояулармен боялады. Романовскийдің әдісімен бруцеллалар нәзік күлгін түске боялады. Грам әдісімен боялмайды. Бруцелланың ауру қоздырғыштық қабілеттілігі және вируленттігі. Бруцеллез індетіне ұшыраған малдың денесінде ауру қоздырғышы негізінен ретикулді - эндотелиалды жүйенің клеткаларында өсіп - өнеді. Мұның өзі бруцелланы клетканың ішінде тіршілік жасайтын қоздырғыштар тобына жататындығын дәлелдейді. Организмге енгеннен кейін қоздырғыш алғашында лимфоидті тканьдерде тоқталып, өсіп - өнеді. Осының нәтижесінде морфологиялық тұрғыдан қарағанда ретикулді - эндотелиалдық пролифераттар және некробиоздық ошақтар пайда болады. Бұл өзгерістердің даму дәрежесі бруцелланың вируленттігіне тікелей байланысты. Вируленттік қасиет - әрбір жеке штамманың өзіндік қасиеті болып есептеледі, былайша айтқанда қоздырғыштың ауру қоздырғыштық қабілетінің сандық көрсеткіші деп есептеуге де болады.
Бруцеллалардың антигендік құрылымы. Бруцеллезбен ауырған не бруцелла микробын еккен жануарлардың қанында тиісті аниттелалар түзіледі. Көптеген өзімізге белгілі организмнің осы қасиетін ауруды анықтап, бруцеллалардың түрлерін табу үшін пайдаланады. Агглютинация реакциясы арқылы бруцелланың сыртқы қабатындағы антигендерді анықтап, диссоциацияға түскен R формасымен диссоциацияға түспейтін S формасын ажыратуға болады. Меер мен Фезье (1921) осы бағытта жұмыстар жүргізгенде жай агглютинация (РА) реакциясымен қатар Кастелланидің агглютининдерді адсорбциялау әдісін пайдаланады. Аурудың қоздырушысы
Ірі қара бруцеллезі
Аурудың сүтке әсері
Сүтті Роз-Бенгал сынағымен зерттеу. Бұл реакция негізінен ірі қара мен қой және ешкі малдарының қаймағы алынбаған жас сүтін сарыпқа қарсы зерттеуге негізделген. Сондай-ақ, әдейі формалин қосып сақталған сүттерді де реакцияға қолданылуға бола береді. Ол үшін 10 мл сүтке 1 тамшы - 0, 03мл 10%-тік формалин ерітіндісін қосқан жөн. Сонымен бірге желінсаумен ауырған малдардың, сүтін суалып кеткен немесе тууға жақын қалған және туғаннан соң алғашқы 12-тәулік аралығында алынған сүттерді бұл реакциямен зерттеуге болмайды.
Реакцияны қою үшін негізінен қанның сарысуын Роз-Бенгал әдісімен зерттегендегі құрал-саймандар қолданылады және оған қосымша мына дәрмектерде қажет:
- тексерілуге алынған сауын сиырдың сүті;
- бенгаль қызғылтымен бояуланған антигені;
- 7%-тік ас содасы (натридің сукабонаты) ;
- ірі қара малдың сарыпқа оң реакция көрсететін сары суы;
- - физиологиялық ерітінді;
- - тазартылған су.


Методические рекомендации "Методы серологической диагностики бруцеллез . . .
Реакцияны таза әдейі арналған, бір немесе бірнеше ойық шұңқыры бар, ақ пластинкаларда, бөлме температурасында қояды. Пластинканың әр бір шұңқырына 0, 03мл тексерілуге алынған сүтті микропипетканың жәрдемімен тамызады. Әр бір жеке сүтті тамызып болғанан соң микропипетканың ұшын үш рет таза дистерленген сумен немесе ауыз сумен шайып соңынан сүзгіш қағаздармен кептіріп отырады. Содан соң әр бір шұңқырдағы сүттер ұйып қалмауы үшін жеке түтікшемен 0, 015мл (бір тамшы) 7%-тік натрийдің сукарбонатын тамызады. Содан соң сүт пен ас содасының ерітіндісін қолдан жасалған 25 араластырғыш таяқшалары бар құрал арқылы мұқият араластырады да әр шұңқырдағы қоспаларға таза түтікшемен 0, 015мл Розбенгал антигенін қосады. Реакцияның барлық қоспаларын жоғарыда айтылған құрал арқылы тағы бір рет тыңғылықты біртүсті болғанша араластырып шығады. Бұдан кейін 4 минут уақыт бойы реакцияны қолмен немесе автоматтық құралдың көмегімен қисайтып қозғап араластырып тұрады. Арналған уақыт өткеннен соң реакцияның көрсеткішін жай көзбен көріп оқиды. Ол үшін реакция қойылған пластинка сәл ғана қисайтып ұстаса болғаны. Егер де реакцияның сұйығы сәл мөлдірленсе және де оның ішінде үлкенді-кіші аглютинациялық қызғылт түсті түйіршіктер пайда болса, онда реакцияны «оң» деп есептейді. Ал реакция шұңқырларында әлгіндегідей өзгерістер болмай, сол бұрынғы қалпында қала, берсе ондай реакцияны «теріс» деп есептейді. Дегенмен де, реакцияның кейбір шүңқырларында түсініксіз, анық байқалмайтын тіптен майда аглютинациялардың болуы мүмкін, ондай нәтиже көрсеткен сүттерді соңынан жинап алып 5-шұңқырға тамызып реакцияны қайтадан қояды да соның нәтижесімен тиісті диагнозды анықтайды.
Негізгі реакцияның дұрыс жүруіне қадағалау үшін 3-шұңқырға тексеру реакциясын жүргізеді.
1) сүттің ұюын тексеру (0, 03мл сүтке 0, 015мл натрийдің, сукарбонатын қосып араластырады да үстіне 0, 015мл антиген тамызады) .
2) Антигеннің кездейсоқ, ішкі себептерден болатын аглютинациясын тексеру (0, 03мл антигенге 0, 03мл физиологиялық ерітінді қосады) .
3) Сүтті тексеру (1 мл сау сиырдың сүтіне 2 тамшы сарыпқа оң реакция беретін қанның сары суын қосады) .
Бұл әдіс мал дәрігерлік тәжірбиесінде кең таралған өте қарапайым, және оңай қойылатын реакция. Реакцияның көлемдігін сауын сиыр арқылы сүтін тексеру арқылы дер кезінде диагнозын анықтап отыруға өте ыңғайлы. Пробиркаға, тексеруге әкелінген қаймағы алынбаған 1 мл сүтті құяды да оған 1-2 тамшы арнайы бояуланған сары антигенін қосып біркелкі шайқау арқылы сүтпен араластырады. Араластырып болған соң пробиркаларды термостатқа немесе су моншасында 1 сағ уақыт 37°-та ұстайды. Егер де зерттеуге алынған сүттің құрамында сарыпқа тән аглютининдер бар болатын болса онда, кейінен қосылған сарып антигендері олармен тікелей байланысқа түсіп, пробиркадағы сүттің ең жоғарғы қабатында көкшіл шеңбер пайда боады, ал сүттің төменгі жаңғы тұнықтанып тұрады. Керісінше, сүттің құрамында сарып ауруына өзіндік, тән аглютиминдер жоқ болатын болса онда, боялған антигендер бос күйінде қалады. Сондықтан пробиркадағы сүттің түсі көкшіл болып оның ең жоғарғы қабатында ақшыл шеңбер түзелді (қаймақ) . Негізінен бұл әдіс бағдарлаушы әдіс болып есептелінеді. Бұл реакциямен желін сауға ұшыраған сиырдың сүтін және жаңадан туған сол сияқты су алуға жақындаған сиырдың сүтін зерттеуге болмайды, өйткені ондай кездерде сол малдардың сүті көп жағдайларда оң әсер беріп қалады. Сарыпқа жатпай тексеру үшін сүтті жаңадан сауып алған өте-мөте ыңғайлы болады. Ол үшін пробиркаларға алдын-ала бір-бір тамшы боялған антигендер құйып қою керек. Содан-соң шетінен алып оған сауынған сүттен шприцпен 1 мл алып қоса салса болды. Барлық пробиркаларды штативке салып су моншасына 37°С тем-да 1 сағ уақыт ұстау қажет.
Сақиналық әдіс. Сүтпен сақина реакциясын ең бірінші рет 1937 жылы Флейшигадэром қойған. Осы серологиялық реакция көмегімен сүт ішіндегі бруцеллезге қарсы антиденені тапқан. Антиген ретінде өлтіріп, боялған бруцеллез миробын пайдаланған. Антиген мен антидене бір-бірімен қосылса ол май түйіршіктеріне шоғырланады да, ал жылы ортада көтеріледі. П. А. Триленко осы реакцияның ерекшелігін ескере отырып, бұның бруцеллезбен күресте өте маңызды екенін айтты, әсіресе ауру малға бірінші рет балау қою үшін өте пайдалы бұл реакцияны зертханалық шалғай жерде қолдана беруге болады. Е. С. Орлов пен О. И. Морякова сақина реакцияның ерекшелігімен сезімталдығын тексеріп, бұған өте жоғары баға берді. Бұл әдіспен сиырдың сүтін ғана емес, жалпы жиналған сүтті де тексеруге болады. Қышқылдығы 30°-тан жоғары және өте майлы сүт бұл әдіспен тексеруге келмейді. Реакцияны қою үшін пробиркаға 0. 05 мл түсті антигенді құйып, оған 1 мл сүт құяды. Сонан соң бір сағат бойы судан шығарып қояды. Көрсетілген мерзім өткеннен кейін реакция қорытындысын тексереді. Болымды реакция болғанда, сүттің беткі жағы қаймақ жиналған жерде көк түсті сақинаны көруге болады. Сүттің басқа қалған қабаты ағарады. реакция өтпеген кезде сүт қабатының түсі бастапқысындай көк болады, демек оның бетінде ешқандай сақина пайда болмайды. Реакцияға жалпы баға бергенде оның активтілігіне қарай крестер қойылады. Тек бір крест қойылған реакциялар есепке алынбайды, басқа көрсеткіштердің барлығын есепке алады. И. И. Архангельский мен В. М. Карташованың айтуы бойынша, бір фляг сүттің ішінде бір ауру сиырдың сүті болса болымды реакция береді.
Электрондық микроскоп арқылы тексергенде бруцеллалардың бір - бірінен және басқа да Грам әдісімен теріс боялатын бактериялардан өзгешелігі байқалмайды. Бруцеллалар барлық анилинді бояулармен боялады. Романовскийдің әдісімен бруцеллалар нәзік күлгін түске боялады. Сонымен қатар көптеген дифференциалды бояу әдістері қолданылады. Бұл әдістер бруцеллардың алғашқы пайдаланылатын бояумен өз бойында берік сақтап қалу қасиетін айқындайды. Осы әдістердің ішіндегі көбірек пайдаланылатыны Е. В. Козловскийдің (1936) әдісі. Бұл тәсіл бойынша ауада кептірілген әйнектегі таңбаны сафраниннің судағы 2 проценттік ерітіндісінде жалынның үстіне ұстап тұрып, ерітіндіде ауа көпіршіктері пайда болғанша бояйды; бұдан кейін ерітіндіні сумен шайып тастап, қосымша малахитті жасылдың судағы 0, 75 - 1 проценттік ерітіндісімен 0, 5 - 1 минуттай бояйды. Бруцеллалар қызыл түске, ал басқа бактериялар, клеткалар жасыл түске боялады. Бруцелла себінділерін өсіру үшін негізінен бактериологияда кеңінен тараған қоректік орталарды пайдалануға болады. Өсу аэробтік (ауаның қатысуымен) жағдайда 37° С температура шамасында жүреді. Бірақ бруцелланың кейбір түрлерін және топтарын өсіру үшін алғашқы кезде ауа құрамында көміртекті газдың (СО2) жоғары шамада (5 - 10 %) болуы талап етілетінін ескеру керек. Бруцеллалар басқа бактерияларға қарағанда қоректік ортаға талғампаз келеді. Сондықтан оларды бөліп алып әрі қарай өсіру үшін арнаулы қоректік орталар ұсынылады. Олардың қатарына бауыр және ет бауырдан дайындалған қоректік орталар, құрамына 2 % глицерин және 1 % глюкоза қосылады. Н. В. Плоскирев ұсынған құрамында балық ұны және дрожды гидролизаты бар құрғақ «Д» қоректік ортасын да бруцеллалар өсу үшін пайдалануға болады.
Ажыратып балау. Алғашқы кездерде аурудың клиникалық белгілері тұрақсыз, белгісіз және де әр малда әртүрлі болып келеді. Сондықтан әсіресе аурудың алғашқы кезеңдерінде белгілерінің айқынсыз ауруға тән болмауының бұл сырқатты басқа да жұқпалы, немесе жұқпалы емес кей кездереде жарақаттың әсерінен болатын аурулардан дұрыс ажырата білудің мәні зор. Бруцеллезді буаз малдар ауырғанда іш тастайтын және төлін шала туатын кампилобактериоз, лептоспироз, қошқардың жұқпалы қарақапталы, сальмонеллез сияқты жұқпалы аурулардан, және де бір қатар жұқпалы емес аурулардан дер кезінде дұрыс анықтай білген жөн. Бруцеллезбен ауырған малды уақтылы дер кезінде клиникалық белгілерінен сүйене отырып басқа індеттерден дұрыс ажыратып алудың мәні бар. Өйткені, көптеген жағдайларда аурудың дұрыс анықталмауының салдарынан қоғамдық малдың тұрақтылығы одан алынатын өнімі төмендеп ара-тұра өлім-жетімге ұшырауына әкеліп соғады.
... жалғасы- Іс жүргізу
- Автоматтандыру, Техника
- Алғашқы әскери дайындық
- Астрономия
- Ауыл шаруашылығы
- Банк ісі
- Бизнесті бағалау
- Биология
- Бухгалтерлік іс
- Валеология
- Ветеринария
- География
- Геология, Геофизика, Геодезия
- Дін
- Ет, сүт, шарап өнімдері
- Жалпы тарих
- Жер кадастрі, Жылжымайтын мүлік
- Журналистика
- Информатика
- Кеден ісі
- Маркетинг
- Математика, Геометрия
- Медицина
- Мемлекеттік басқару
- Менеджмент
- Мұнай, Газ
- Мұрағат ісі
- Мәдениеттану
- ОБЖ (Основы безопасности жизнедеятельности)
- Педагогика
- Полиграфия
- Психология
- Салық
- Саясаттану
- Сақтандыру
- Сертификаттау, стандарттау
- Социология, Демография
- Спорт
- Статистика
- Тілтану, Филология
- Тарихи тұлғалар
- Тау-кен ісі
- Транспорт
- Туризм
- Физика
- Философия
- Халықаралық қатынастар
- Химия
- Экология, Қоршаған ортаны қорғау
- Экономика
- Экономикалық география
- Электротехника
- Қазақстан тарихы
- Қаржы
- Құрылыс
- Құқық, Криминалистика
- Әдебиет
- Өнер, музыка
- Өнеркәсіп, Өндіріс
Қазақ тілінде жазылған рефераттар, курстық жұмыстар, дипломдық жұмыстар бойынша біздің қор #1 болып табылады.



Ақпарат
Қосымша
Email: info@stud.kz